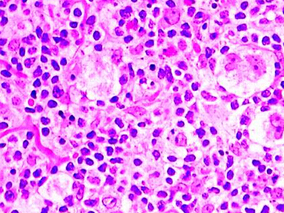
新的化疗方案或能改善复发性难治性霍奇金淋巴瘤患者结局

-
良恶性唾液腺肿瘤鉴别:高时间分辨率DCE-MRI的诊断…
环球医学资讯
2016年02月05日
点击量:622
1小时条评论尽管几项研究已经报告了DCE-MRI在区分唾液腺肿瘤诊断中的有效性,但应用的特异性诊断标准广泛不同。该研究旨在确定使用动态序列联合高时间分辨率动态增强MRI(DCE-MRI)预测唾液腺恶性肿瘤的最佳诊断标准以及该技术的准确度。相关报告发表在2015年《Br J Radiol.》。...
-
儿童期肿瘤存活者接受放疗和蒽环类后具有高剂量依赖…
环球医学资讯
2016年02月03日
点击量:420
1小时条评论儿童期接受肿瘤治疗的患者,心脏损害是其主要的副作用之一。2016年1月,发表在《Circulation》的一项研究显示,接受放疗和蒽环类药物治疗的儿童期肿瘤存活者存在高剂量依赖心脏疾病发生风险。 nbsp; 背景:心脏疾病(CD)是儿童期肿瘤治疗的主要副作用之一,但至今...
-
乳腺癌化疗期间使用LHRH诱导的卵巢抑制的长期结果
环球医学资讯
2016年02月02日
点击量:283
1小时条评论曲普瑞林主要用于前列腺癌的治疗。2015年12月发表在《JAMA》的一项在意大利开展的研究,评估了乳腺癌化疗期间使用LHRH诱导的卵巢抑制的长期结果。 重要性:由于缺少长期卵巢功能和妊娠数据,同时对内分泌治疗和化疗之间潜在的负向相互作用引起的安全性问题的担忧,...
-
胶质母细胞瘤的维持治疗:肿瘤治疗电场+替莫唑胺vs…
环球医学资讯
2016年02月02日
点击量:367
1小时0条评论胶质母细胞瘤是最常见的颅内恶性肿瘤。2015年12月发表在《JAMA》的一项由瑞士、法国、以色列等国科学家进行的研究表明,肿瘤治疗电场联合替莫唑胺可以延长胶质母细胞瘤患者的无进展生存期和总生存期。 重要性:胶质母细胞瘤是成年人中枢神经系统的最具破坏性的原发...
-
骨化三醇、阿司匹林联合碳酸钙不能预防3年内结直肠…
环球医学资讯
2016年01月27日
点击量:519
1小时条评论大部分结直肠癌都是散发的,并在几年内以腺瘤-肿瘤的形式发生,常使用化学药物进行预防。2016年1月,发表在《Gastroenterology》的一项前瞻性研究显示,骨化三醇、阿司匹林和碳酸钙联合不能预防3年内结直肠腺瘤的复发。 nbsp; 背景和目的:化学预防策略可能被用于...
-
乳腺癌绝经后女性:芳香化酶抑制剂治疗严重影响椎体…
环球医学资讯
2016年01月26日
点击量:399
1小时条评论绝经后乳腺癌患者与同龄健康女性相比,骨丢失进一步加速,骨折风险升高,使得病残率和死亡率增加。芳香化酶抑制剂(AI)能够明显改善乳腺癌患者的生存率,但同时也降低雌激素水平,因此会加速患者的骨丢失,增加骨折风险。2016年1月,发表在《Menopause》的一项临床...
-
长效PPI的肿瘤风险高于短效PPI?
环球医学资讯
2016年01月22日
点击量:658
1小时条评论有研究发现,PPI可刺激体外培养的肿瘤细胞生长。长效PPI是否比短效PPI肿瘤风险更高呢?2016年1月,发表在《Alimen tary Pharmacology amp; Therapeutics》的一项上市后监测研究发现,目前没有证据支持长效PPI泮托拉唑与短效PPI相比会导致更高的胃癌、胃肠道肿瘤和其...
-
紫杉醇阈值浓度监测:Excel工具vs NONMEM软件
环球医学资讯
2016年01月21日
点击量:515
1小时条评论紫杉醇主要用于治疗卵巢癌和乳腺癌。2015年12月发表在《Therapeutic Drug Monitoring》的一项研究,比较了用于紫杉醇阈值浓度监测的Excel工具和NONMEM软件。 nbsp; 背景:嗜中性粒细胞减少症是接受紫杉醇化疗的患者中常见且严重的不良事件。当紫杉醇阈值浓度超过0....
-
导管内注射对比剂的高分辨率3D MRI或可测量乳腺导管…
环球医学资讯
2016年01月15日
点击量:143
1小时条评论乳腺癌是全世界妇女癌症中最常见的原因。早期发现乳癌具有改善乳腺癌患者生活质量和存活的关键作用。大多数乳腺恶性肿瘤开始由上皮细胞中的导管或小叶,因此导管是重要的研究区域。本研究的目的为使用高分辨率三维(3D)核磁共振成像(MRI)技术,基于导管内注射对比...
-
新的化疗方案或能改善复发性难治性霍奇金淋巴瘤患者…
环球医学资讯
2016年01月14日
点击量:303
1小时条评论2015年10月,发表在《Br J Haematol》的一篇文章显示,复发性/难治性霍奇金淋巴瘤患者使用新的基于福莫司汀的高剂量化疗方案或能改善结局。 nbsp; 高剂量化疗(HDT)联合自体干细胞移植是复发性/难治性(RR)霍奇金淋巴瘤(HL)的标准治疗方法。鉴于HDT能治愈相当...

会员登录

